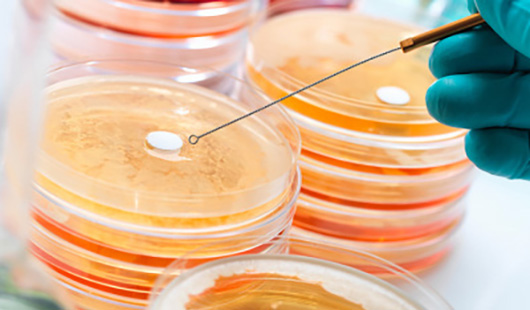
欧盟食品接触材料测试

检测服务

食品接触材料
提供以下产品检测: 餐具:刀叉、碗、筷、勺、杯、碟等食品接触材料
厨具:储藏用具、洗涤用具、调理用具、烹调用具等
食品包装容器:纸容器、金属容器、玻璃容器、塑料容器、塑料包装袋/膜等
厨房家电:燃气灶、油烟机、烤箱、微波炉、消毒柜、洗碗机、榨汁机、搅拌机、咖啡机、电水壶、电饭煲、电磁炉等(此类暂时我们公司无相应业务)
儿童用品:婴儿奶瓶、安抚奶嘴、婴儿用饮水杯等
》提供以下检测项目
常规项目 特定迁移
微生物指标 其他项目 感官要求
总迁移量
高锰酸钾消耗量
重金属(以Pb计)
铅(Pb)、镉(Cd)、铬(Cr)、镍(Ni)、砷(As)、锑(Sb)、锌(Zn)等重金属迁移量
甲醛、酚、芳香胺、氯乙烯、偏二氯乙烯
大肠菌群
致病菌(志贺氏菌/沙门氏菌/金黄色葡萄球菌/溶血性链球菌)
霉菌
荧光性物质
脱色试验
干燥失重
灼烧残渣
正己烷提取物等
》食品接触法规新国标框架体系
新的食品接触材料法规框架体系中包括了通用标准、生产规范、产品标准以及检验方法标准。
【通用标准】
GB 4806.1 《食品安全国家标准 食品接触材料及制品通用安全要求》
GB 9685《食品安全国家标准 食品接触材料及制品用添加剂使用标准》 【生产规范】 GB 31603 《食品安全国家标准 食品接触材料及制品生产通用卫生规范》
【产品标准】
GB 4806.2~11对应的搪瓷、陶瓷、玻璃、树脂、塑料、纸和纸板、金属、涂料及涂层、橡胶等材质的食品接触材料及制品标准。后续还会制定竹木制品、粘合剂、复合材料、油墨、润滑剂、纺织纤维等产品标准。
【检验方法】
GB 31604.1 《食品接触材料及制品迁移试验通则》
GB 5009.156 《食品安全国家标准 食品接触材料及制品迁移试验预处理方法通则》
GB 31604.2~49食品接触材料及制品测试方法标准
GB 9685《食品接触材料及制品用添加剂使用标准》符合性评价的必要性
| 常规项目 | 特定迁移 | 微生物指标 | 其他项目 |
感官要求 总迁移量 高锰酸钾消耗量 重金属(以Pb计) | 铅(Pb)、镉(Cd)、铬(Cr)、镍(Ni)、砷(As)、锑(Sb)、锌(Zn)等重金属迁移量 甲醛、酚、芳香胺、氯乙烯、偏二氯乙烯 | 大肠菌群 致病菌(志贺氏菌/沙门氏菌/金黄色葡萄球菌/溶血性链球菌) 霉菌 | 荧光性物质 脱色试验 干燥失重 灼烧残渣 正己烷提取物等 |
新的食品接触材料法规框架体系中包括了通用标准、生产规范、产品标准以及检验方法标准。
【通用标准】
GB 4806.1 《食品安全国家标准 食品接触材料及制品通用安全要求》
GB 9685《食品安全国家标准 食品接触材料及制品用添加剂使用标准》 【生产规范】 GB 31603 《食品安全国家标准 食品接触材料及制品生产通用卫生规范》
【产品标准】
GB 4806.2~11对应的搪瓷、陶瓷、玻璃、树脂、塑料、纸和纸板、金属、涂料及涂层、橡胶等材质的食品接触材料及制品标准。后续还会制定竹木制品、粘合剂、复合材料、油墨、润滑剂、纺织纤维等产品标准。
【检验方法】
GB 31604.1 《食品接触材料及制品迁移试验通则》
GB 5009.156 《食品安全国家标准 食品接触材料及制品迁移试验预处理方法通则》
GB 31604.2~49食品接触材料及制品测试方法标准
GB 9685《食品接触材料及制品用添加剂使用标准》符合性评价的必要性
-

美国FDA测试
-
欧盟食品接触材料测试
-

中国食品接触材料测试
-

美国食品接触材料测试
为什么选择我们?
 多年经验,提供检测方案及建议
多年经验,提供检测方案及建议
南京慧测检测技术有限公司(HUI慧测)成立于2022年,是一家集检验检测、技术研发、技术咨询指导为一体的专业第三方检测机构,公司以客户为中心,以高技术人才队伍为基础,以科学、严谨、精准、公正为基本行为准则,以技术共享为平台,为各企事业单位提供检验检测、咨询检定、质量控制一站式服务。
 深度合作国际认证机构
深度合作国际认证机构
获得中国合格评定国家授权委员会(CNAS)认可实验室,美国消费品安全委员会(CPSC)认可实验室,以及检验检测机构计量认证(CMA)认可实验室等资质。检测报告在国际实验室认可合作组织(ILAC)成员内获得互认。
 根据不同行业和需求制定方案
根据不同行业和需求制定方案
拥有经验丰富的检测认证专家团队和专业齐全的检测设施,专门从事亚马逊CPC认证、箱包/手袋、服装与纺织品、玩具婴童用品、鞋类与皮革、饰品配饰、食品接触材料、电子电器及周边产品等领域。
 专业检测认证团队&齐备的检测设施
专业检测认证团队&齐备的检测设施
致力于协助企业从产品研发、材料挑选、生产流程到出货进入市场各个环节提供服务,通过提供专业快捷的质量与安全合规解决方案,为您的产品远销世界各地保驾护航。以专业化的服务和技术,赢得了国内外众多客户的信任。
